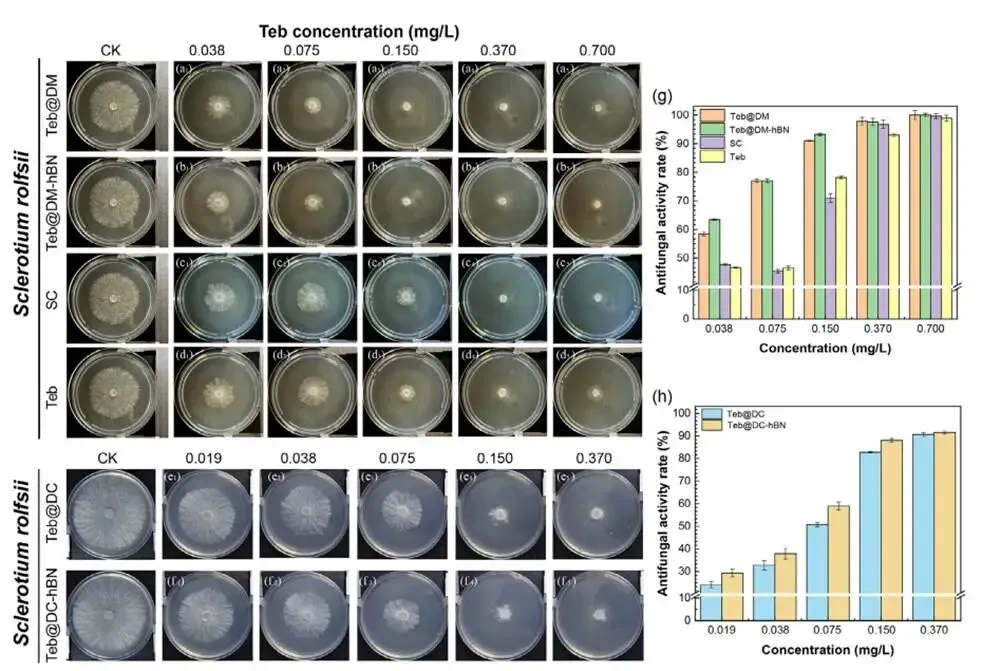

【好文分享】仲恺农业工程学院李浩教授团队《Advanced Science》IF=14.1新突破:刺激响应性超分子凝胶纳米杀菌剂
仲恺农业工程学院李浩教授团队2025年11月19日在《Advanced Science》(Q1,中科院1区Top,IF=14.1,DOI: 10.1002/advs.202515855)发表题目为“Boron nitride reinforced supramolecular gels nano-Assembled with fungicides toward soil-borne fungal disease management”的研究论文。

一、研究背景
土传真菌病原体(如齐整小核菌引起的白绢病)对现代农业构成重大威胁,影响超过600种植物,造成严重经济损失。传统杀菌剂(如三唑类)在输送过程中存在诸多局限性,包括快速光降解、土壤基质渗透性差、环境扩散不受控制等。常规剂型(如悬浮剂、乳油)依赖表面活性剂和有机溶剂,虽有助于初始分散,但无法将杀菌剂递送至目标部位,导致其快速淋溶至地下水并从根际扩散。因此,亟需开发一种能够实现选择性、长期积累于病原体-植物-土壤界面的智能输送系统。
二、研究创新点
本研究提出了一种全新的策略,将二维纳米材料六方氮化硼(h-BN)与刺激响应性超分子凝胶相结合,设计并制备了一种用于精准农业的纳米组装杀菌剂输送系统。其核心创新点在于:
1. 主动功能化设计:h-BN纳米片并非作为被动填料,而是作为材料结构和功能的主动、不可或缺的组成部分。它通过其多价表面,同时与杀菌剂的芳香环发生π-π堆积、与凝胶剂的烷基链进行疏水锚定、并通过其边缘位点与多元酸形成氢键。
2. 协同组装与多重刺激响应:系统通过氨基酸胶(DMPSA)、多元酸(MA或CA)、杀菌剂戊唑醇(Teb)和h-BN纳米片的一锅法共组装而成。这种多组分方法产生了具有竞争性相互作用模式(离子键、氢键、芳香相互作用)的受挫超分子结构,从而赋予材料pH和温度双重刺激响应的凝胶-溶胶转变及药物释放行为。
3. 性能的多功能集成:该设计首次在软物质系统中实现了2D材料介导的刺激响应性传输,开创了一类具有可编程渗透特性的纳米桥联载体。它同时集成了优异的机械稳定性、增强的界面粘附性、改善的土壤持久性以及降低的环境毒性。
三、 研究结果

应用场景及优势示意图
1. 凝胶微观结构、组分相互作用及通用载药平台验证
冷冻及溶胶态SEM图像显示,不同组分显著影响凝胶微观结构:Teb的加入使DM、DC凝胶层状结构更紧密有序,证实其起到桥接稳定作用;h-BN纳米片则以疏水作用嵌入纤维网络,作为物理交联剂增强交联密度、收窄孔径。粒径分析表明,Teb的疏水作用能引起组装体收缩,pH变化通过质子化/去质子化调节静电与氢键作用,进而影响尺寸,而h-BN的引入则因空间位阻大幅增加粒径。研究还证实该平台对吡虫啉、噻虫嗪等多种杀菌剂具有通用载药能力。

图1 冷冻干燥及溶胶态超分子凝胶的微观形貌与粒径分布表征,展示了不同组分(Teb、h-BN、多元酸)及pH条件对材料结构的影响
2. 温敏与pH响应特性协同调控凝胶流变性能
超分子凝胶表现出显著的温敏与pH响应特性。Teb@DM粘度在58℃达到峰值(4850 mPa·s),源于氢键与疏水作用的动态平衡;h-BN的加入可提前峰值温度并提升粘度至5400 mPa·s。Teb@DC则因CA的离子交联在35-58 ℃保持稳定,高温下因去质子化触发疏水重组,实现粘度恢复。两种凝胶均呈现剪切稀化行为,利于喷雾应用。pH通过调控基团质子化/去质子化影响粘度:Teb@DM在酸性下粘度升高,碱性下降低;Teb@DC变化较小。h-BN的引入使零剪切粘度提升3-5倍,并在高剪切下保持较高强度,显著增强了凝胶的机械稳定性和网络完整性。热重分析表明,Teb的加入使DM与DC凝胶的碳链分解温度偏移至309℃,提升了热稳定性;h-BN的引入则进一步增强了相变过程的动力学稳定性。DSC分析证实了凝胶具有可逆的热循环特性:Teb@DM呈现三重吸热峰,而DC体系峰形更单一,Teb的加入引入了轻微异质性。

图2 不同组分与pH条件下超分子凝胶的流变性能、热稳定性及热行为表征
3. 相变行为与分子间作用机制解析
通过zeta电位、电导率、FTIR、核磁、XRD及XPS等综合表征,系统揭示了各组分间的复杂相互作用:Teb通过π-π堆积、氢键(尤其与MA/CA中羧基作用,使其三唑环N质子化)及疏水作用嵌入凝胶网络和h-BN层间,并有效调控局部电荷环境;h-BN则通过静电与介电效应显著提升体系zeta电位。这些作用协同增强了结构的稳定性与响应特性。

图3 流变行为Teb的粘度变化曲线
4. 载药性能、pH/温度响应释放行为及调控机制
超分子凝胶对多种杀菌剂展现出良好的通用负载性能(包封率>80%,负载量20-25%)。释放行为高度依赖活性成分的分子结构及环境响应:不同杀菌剂在DM凝胶中的释放速率差异显著(如Thi@DM最慢),体现了氢键与疏水作用的调控。Teb的释放表现出明确的pH与温度双重响应:在DM体系中,酸性条件收紧网络抑制释放,碱性条件加速释放;h-BN的引入通过疏水与π-π作用进一步延缓释放。在DC体系中,强离子网络使pH=3(液态)与pH=11(键破坏)时释放更快,h-BN影响甚微。温度影响则更为复杂:在DM中,25℃时释放最快,40℃时因疏水作用致密化而减速,55 ℃时氢键断裂可能短暂加速;h-BN的骨架作用能平抑这种波动。在DC中,温度通过差异性地调控离子力、疏水力与氢键三重相互作用,同样实现了释放速率的开关式调控。这些结果表明,凝胶网络的多重相互作用可作为“分子开关”,实现对药物释放行为的精准编程。

图4 不同杀菌剂在DM凝胶中的包封率/负载量及释放曲线,以及Teb在DM/DC体系及其h-BN增强体系中受pH、温度调控的响应性释放行为
5. 超分子凝胶显著增强叶面润湿性与粘附性
研究表明,超分子凝胶体系(DM/DC及其Teb、h-BN复合物)在疏水黄瓜叶片上展现出卓越的润湿与粘附性能。其动态接触角显著低于市售悬浮剂,且能持续降低,实现液滴自铺展,得益于DMPSA的表面活性、与蜡质的氢键作用及h-BN促进的界面渗透。表面张力滴定显示DM体系具有较低的临界胶束浓度和表面张力,润湿效率高;而DC因柠檬酸结构致使其CMC较高,胶束稳定性较低,但对pH触发释放更敏感。粘附性测试表明,凝胶通过DMPSA的长链、酸的氢键及h-BN的疏水作用协同增效,使Teb@DM-hBN的叶片保留量较纯水提升超过50%,有效减少了药液滚落损失,提升了农药利用率。

图5 不同超分子体系(含Teb、h-BN等)在黄瓜叶片上的动态接触角、表面张力及液体保持能力测试,并与水和常规制剂(SC/STAB)对照比较
6. 荧光成像证实凝胶显著提升抗雨水冲刷能力
荧光显微镜观察表明,经模拟降雨冲刷后,游离Teb及市售SC制剂的荧光信号几乎或大量消失,而超分子凝胶(DM/DC及其含Teb、h-BN的复合物)在叶片表面仍保持高强度荧光。这证实了凝胶体系通过氢键、静电作用及h-BN的强亲和力,显著增强了在疏水叶片上的粘附性与抗雨蚀性能,有效减少了农药流失。

图6 不同超分子凝胶(DM/DC及其含Teb、h-BN的复合物)、游离Teb及市售SC在黄瓜叶片表面冲洗前后的荧光图像对比
7. 土壤吸附、解吸与滞留行为揭示载体调控作用
土壤吸附与解吸研究表明,游离Teb吸附最强但解吸最慢,而超分子载体改变了其土壤行为:DC载体倾向于快速释放(解吸快),DM载体支持缓释,h-BN的引入则通过增强与土壤的界面作用,显著提升了复合载体(如Teb@DC-hBN)的吸附与滞留能力。土壤柱淋洗实验证实,h-BN增强的超分子凝胶在土壤中滞留时间最长(可达940 min),远优于游离Teb和常规制剂。花生根浸渍试验进一步表明,Teb@DM-hBN在根部的粘附滞留率最高(41.45%)。这些结果证明,通过选择载体类型和引入h-BN,可精准调控农药在土壤中的吸附、释放与滞留性能,从而实现长效保护并降低淋溶风险。

图7 沙壤土对游离Teb及其超分子复合物的吸附等温线、解吸释放曲线、土壤柱淋洗滞留时间及在花生根部的粘附滞留能力对比
8. 超分子凝胶协同增强抗真菌活性与持续性
研究表明,Teb@DM与Teb@DC超分子体系的抗真菌活性显著优于游离Teb及市售悬浮剂(SC),其EC50值更低。随时间推移,凝胶体系因缓释特性保持更高的抑制率(如第6天Teb@DM-hBN达80.27%),证实其延长了药效。这种增强源于双重机制:一是DM/DC载体本身具有阳离子表面活性剂样结构,能破坏真菌细胞膜;二是其纳米尺寸与可控释放特性提升了Teb的生物利用度与作用持续性。h-BN的引入进一步优化了释放动力学,协同增强了防治效果,实现了在更低浓度下的高效抑菌。
图8 不同Teb浓度下,游离Teb、市售SC、Teb@DM、Teb@DM-hBN、Teb@DC及Teb@DC-hBN对菌核病的抑制活性图像与抑制率直方图
9. 盆栽试验证实优异防病、促生与生物安全性
21天盆栽试验表明,Teb@DM与Teb@DM-hBN能有效抑制土壤中病原菌丝扩展,保护花生茎根免受侵染,并显著促进植物生长(如根系增重、分枝增多、叶片生长加速)。该体系还展现出卓越的生物安全性:相较于游离Teb与市售SC对种子发芽的显著抑制(发芽率约60%),DM/DC载体本身具有保水与促呼吸作用,能提升发芽率(>75%/95%),并将Teb封装后大幅减轻其植物毒性;细胞毒性实验进一步证实,超分子凝胶能显著缓解Teb的细胞毒性,提升细胞存活率。h-BN的引入在增强防效的同时,未增加体系毒性。这全面验证了该智能载药系统高效、安全、环保的综合优势。

图9 不同处理(含CK、Teb、SC、Teb@DM、Teb@DM-hBN等)下花生盆栽的抗病效果、植株/根系生长指标、种子发芽率及对NIH3T3细胞的毒性对比
四、结论
本研究成功开发了一种h-BN增强的超分子凝胶纳米组装系统(Teb@DM-hBN和Teb@DC-hBN),用于土传真菌病害的可持续管理。该系统通过协同整合超分子凝胶的微环境响应性和h-BN的粘附与结构特性,克服了传统杀菌剂的局限性。其创新之处在于将h-BN作为主动功能组分,实现了双重刺激响应释放、机械性能增强、界面粘附性提升、土壤持久性延长以及环境安全性改善。盆栽试验证实了其卓越的防效和促生长作用,为设计下一代智能、环保的农药输送系统提供了新思路。
文章出处:
Li Hao, Jialin Zeng, Weixian Qiu, Jinhui Wang, Xiaoshan Huang, Jiachun Wu, Zhensong Weng, Ziting Yin, Hongjun Zhou, and Xinhua Zhou, Advanced Science, 2025,15888, 2-21.
原文链接:
https://doi.org/10.1002/advs.202515855
图文|王安琪
一审|刘妍妍
二审|李凤瑞
三审|高爽